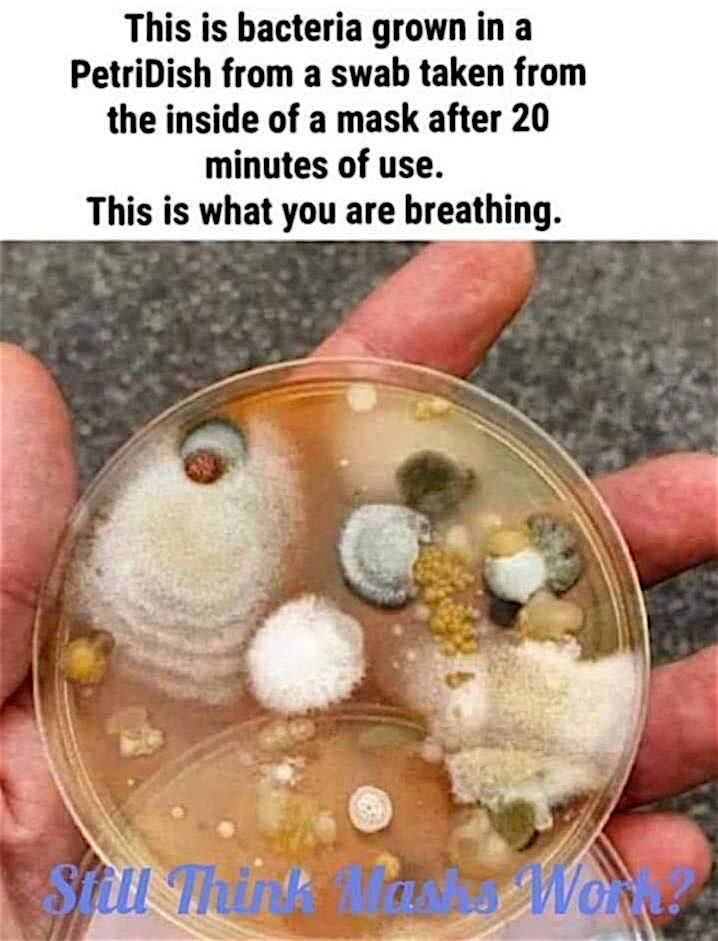

I did wonder on a Qantas flight a few months ago, at the toxic smell that I had to endure during my flight. Luckily I could remove it for most of the flight despite the rule of remaining masked “except whilst eating or drinking”. This type of damage to childrens’ lungs is extremely worrying. Children as young as two years old are being forced to remain masked for 6 to 8 hours per day in some places. The public health advocates stating we will be dealing with the fallout of this insanity for generations seem to be correct in ways that we are yet to understand.
From Government of Canada: